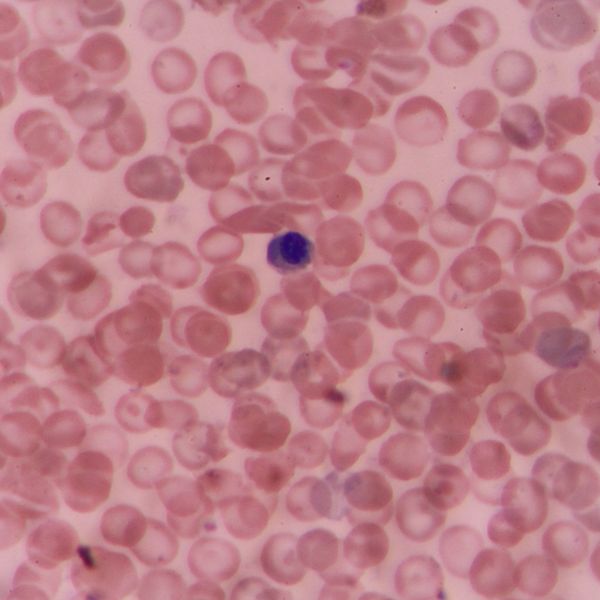

หนึ่งในเทรนด์หัตถกรรมสำหรับผู้ที่มีปัญหาริ้วรอยแห่งวัย และพอมีเงินทุนอยู่บ้าง เชื่อว่าหนึ่งในหัตถกรรมที่ตอบโจทย์คุณได้ดี คงหนีไม่พ้นกับสเต็มเซลล์ หรือที่หลายคนมักเรียกกันว่าสเต็มเซลล์ฟื้นฟูแน่นอน เพราะนี่เป็นหัตถกรรมที่ใช้เซลล์เพื่อฟื้นฟูเซลล์ ซึ่งเป็นหัตถกรรมที่ก้าวหน้า และไปไกลมากกว่ารูปแบบอื่น ๆ
เบื้องต้นอาจจะต้องเกริ่นให้ทุกคนได้เข้าใจ และรู้ที่มาที่ไปของสเต็มเซลล์กันเสียก่อน สเต็มเซลล์เป็นเซลล์ที่ยังไม่พัฒนาเป็นเซลล์อวัยวะใดอวัยวะหนึ่ง มีหน้าที่หลักในการฟื้นฟู และซ่อมแซมส่วนที่สึกหรอเป็นหลัก ร่างกายสามารถผลิตเองได้ แต่เมื่ออายุมากขึ้น เซลล์ประเภทนี้จะเสื่อมสภาพ และไม่สามารถสร้างขึ้นมาใหม่เองได้ นั้นทำให้การฉีดสเต็มเซลล์จึงเป็นคำตอบสำหรับผู้ที่กังวลเรื่องปัญหาผิว และร่างกายเสื่อมสภาพนั้นเอง ในบทความชิ้นนี้จะพาทุกคนไปเจาะลึกกับสเต็มเซลล์ฟื้นฟูนี้กันให้ลึกซึ้งมากยิ่งขึ้น

ได้พูดถึงสเต็มเซลล์ไปบ้างแล้วในเนื้อหาก่อนหน้าว่าจริง ๆ แล้วสเต็มเซลล์นี้คือเซลล์ที่มีในร่างกายของมนุษย์ แต่ยิ่งอายุมาก เซลล์นี้จะค่อย ๆ เสื่อมสภาพไปตามกาลเวลา ตัวอย่าง เด็กทารกที่เกิดมามีสเต็มเซลล์ 100% เมื่ออายุ 30 ปี สเต็มเซลล์นั้นกลับเหลือในร่างกายเพียง 30% แน่นอนว่าหลังจากนั้นสเต็มเซลล์ก็จะลดจำนวนลงเรื่อย ๆ อย่างต่อเนื่องตามอายุ
และสภาวะนี้นี่เองที่ทำให้ร่างกายไม่แข็งแรง มีปัญหาแผลแห้งยาก หรือแผลไม่ยอมปิด ที่ลามไปถึงปัญหาที่กวนใจใครหลายคนอย่างปัญหาริ้วรอยแห่งวัย ตีนกา ฝ้า กระ จุดด่างดำ หรือแม้กระทั่งรอยสิวที่หายได้ยาก ทุกอย่างที่พูดมานั้นเกิดจากการที่สเต็มเซลล์ในร่างกายทำงานได้ไม่เต็มที่จากสภาพเซลล์ที่ไม่แข็งแรง
การได้สเต็มเซลล์ฟื้นฟูเข้าสู่ผิว จะช่วยทำให้เกิดการเร่ง และกระตุ้นสเต็มเซลล์ของผิวที่เหนื่อยล้า ให้กลับมาพร้อมทำงาน และฟื้นฟูอวัยวะต่าง ๆ ของร่างกายได้ดีขึ้น จึงไม่น่าแปลกที่หลังจากฉีดสเต็มเซลล์ไป ผลลัพธ์ที่เห็นได้ชัดเจนมากในช่วงแรกคือใบหน้าที่อิ่ม สดใส และริ้วรอยบนใบหน้าดูตื้นขึ้น
สเต็มเซลล์นั้นไม่ได้มีเพียงประเภทเดียว เพราะถ้าหากลงรายละเอียดเรื่องเซลล์ประเภทนี้แล้ว จะพบว่าสเต็มเซลล์ฟื้นฟูนั้นถูกแบ่งออกเป็น 2 ประเภทใหญ่ ๆ ได้แก่ สเต็มเซลล์จากตัวอ่อน (Embryonic Stem Cells) และ สเต็มเซลล์จากผู้ใหญ่ (Adult or Somatic Stem Cells)
นี่เป็นสเต็มเซลล์ที่มีประสิทธิภาพมากที่สุด แต่ยังไม่มีการรองรับ หรืออนุญาตให้นำไปใช้ได้ เนื่องจากการคัดแยกสเต็มเซลล์ประเภทนี้ผิดจริยธรรมอีกด้วย
สเต็มเซลล์ที่มีการใช้อย่างแพร่หลาย พบได้ในไขมัน, ไขกระดูก, รก และสายสะดือ ความน่าสนใจของสเต็มเซลล์ประเภทนี้นั้นจัดได้ว่าเป็นเซลล์ที่ต้นกำเนิด หมายถึงเซลล์ประเภทนี้ยังไม่ได้มีการเจริญเติบโตไปเป็นเซลล์ของอวัยวะใดอวัยวะหนึ่ง หน้าที่หลักที่เซลล์นี้ทำคือการฟื้นฟู และซ่อมแซมอวัยวะที่เป็นปัญหา เมื่อพบว่าเซลล์ใดมีจุดบกพร่อง หรือเสื่อมสภาพก็จะพัฒนาตัวเอง และไปทดแทนอวัยวะในส่วนที่มีปัญหา เป็นสเต็มเซลล์ที่มีการนำไปใช้เพื่อทำหัตถกรรมในปัจจุบันนั้นเอง
แพทย์หลาย ๆ คนมักจะพูดว่าการฉีดสเต็มเซลล์นั้นเป็นการบำบัด ไม่ใช่การรักษา เนื่องจากการฉีดสเต็มเซลล์เข้าสู่ร่างกายนั้น ไม่ใช่การให้สเต็มเซลล์ที่ฉีดไปทดแทน หรือทำหน้าที่แทนเซลล์เก่าที่มีอยู่ในร่างกาย แต่การฉีดสเต็มเซลล์เข้าไปนั้นคือการกระตุ้น และเสริมแรงให้กับสเต็มเซลล์ที่มีอยู่ในร่างกายให้สามารถทำงานได้เต็มที่ และกลับมาแข็งแรงอีกครั้ง

ใครที่กำลังสนใจ และอยากลองฉีดสเต็มเซลล์กัน หนึ่งในคำถามที่อยู่ในใจของแต่ละคน คงหนีไม่พ้นกับข้อกังวลอย่างเรื่องความปลอดภัยในการรักษาว่ามีความปลอดภัยมากน้อยเท่าไหร่ การรักษาด้วยการฉีดสเต็มเซลล์นั้นในปัจจุบันยังไม่มีการรายงานว่าพบอาการแพ้ หรือมีผลข้างเคียงในการทำหัตถกรรมประเภทนี้ (ข้อมูลจากองค์การอาหารและยาของสหรัฐ) แต่ก็มีเรื่องน่าห่วงอย่างการคัดเลือนสเต็มเซลล์จากทางแล็บ
ที่นี่จะเป็นขั้นตอนที่มีความสำคัญอย่างมาก เนื่องจากทางแพทย์ผู้รักษาจะทำการวิเคราะห์ปัญหาผิวของแต่ละเคส และแจ้งการสั่งสเต็มเซลล์กับทางแล็บที่เป็นผู้จัดจำหน่าย ซึ่งจะต้องใช้ระยะเวลาประมาณ 7 วัน ให้ทางแล็บได้ทำการเพาะ และคัดเลือกสเต็มเซลล์ที่แข็งแรงที่สุด แน่นอนว่าการคัดเลือกนี้ควรจะเป็นการคัดเลือกสเต็มเซลล์ด้วยผู้เชี่ยวชาญเท่านั้น เนื่องจากต้องใช้ทั้งประสบการณ์ และความรู้เฉพาะทาง สิ่งที่คุณทำได้คือการสอบถามแพทย์ผู้สั่งสเต็มเซลล์เกี่ยวกับระดับความชำนาญของผู้จัดจำหน่ายสเต็มเซลล์ หรือใบรับรอง เพื่อให้มั่นใจได้ว่าสเต็มเซลล์ที่จะเข้ามาอยู่ในร่างกายคุณนั้นจะปลอดภัย หายห่วง
นี่เป็นข้อมูลทั้งหมดที่คัดมาให้ผู้ที่กำลังวางแผนอยากไปรักษาปัญหาผิว หรือปัญหาสุขภาพด้วยการฉีดสเต็มเซลล์ หรือ สเต็มเซลล์ฟื้นฟู หวังว่าจะเป็นประโยชน์ต่อการตัดสินใจเข้าใช้บริการได้เป็นอย่างดี ใครที่มีคำถาม หรือข้อสงสัยเกี่ยวกับสเต็มเซลล์ ควรเข้าไปปรึกษากับแพทย์ผ่านทางโรงพยาบาล หรือคลินิกที่ต้องการใช้บริการ เนื่องจากแพทย์จะต้องวิเคราะห์ปัญหา และคาดการณ์จำนวนสเต็มเซลล์ที่ต้องใช้เสียก่อน
Ref.
ทำความรู้จักสเต็มเซลล์และประโยชน์ของสเต็มเซลล์ - Stemcellforlife
